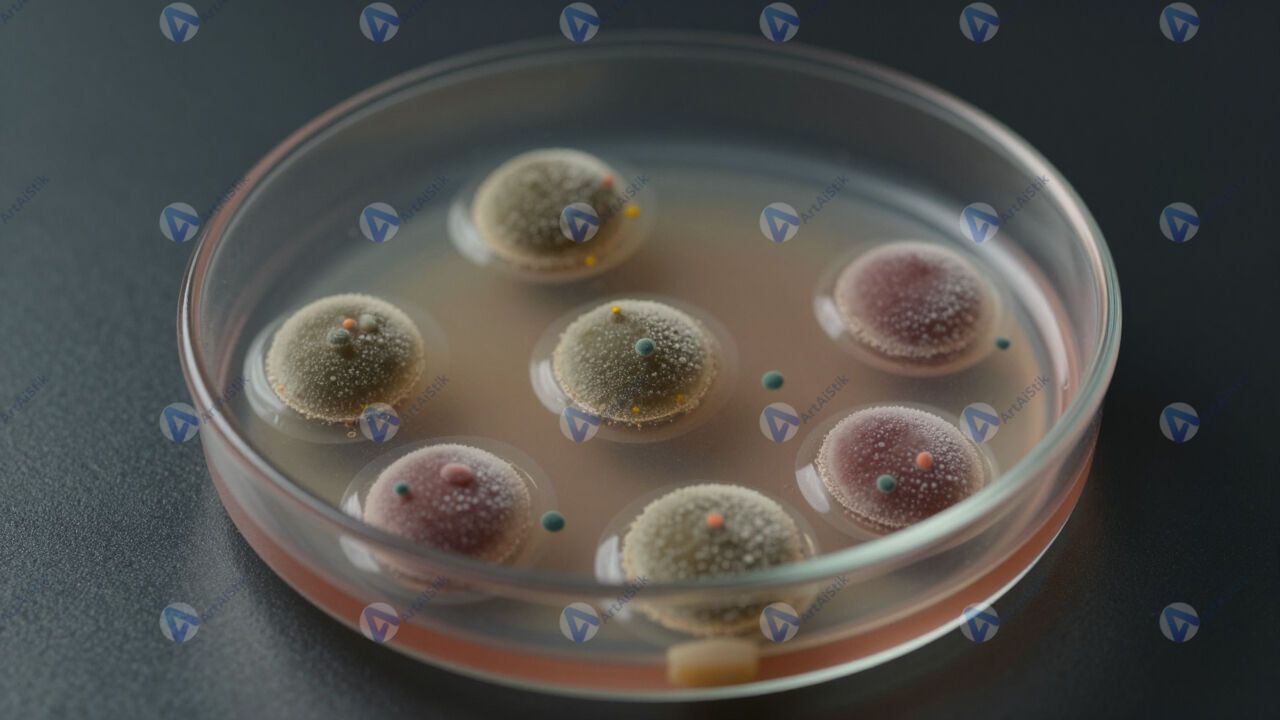

Чаша Петри с колониями бактерий под стеклянной крышкой.
Размер: 1280х720 px
Чтобы скачать картинки сначала следует оплатить услугу генерации изображений. После оплаты вам будут предоставлены ссылки на все изображения представленные в карточке.
Для оплаты нажмите кнопку «В корзину».